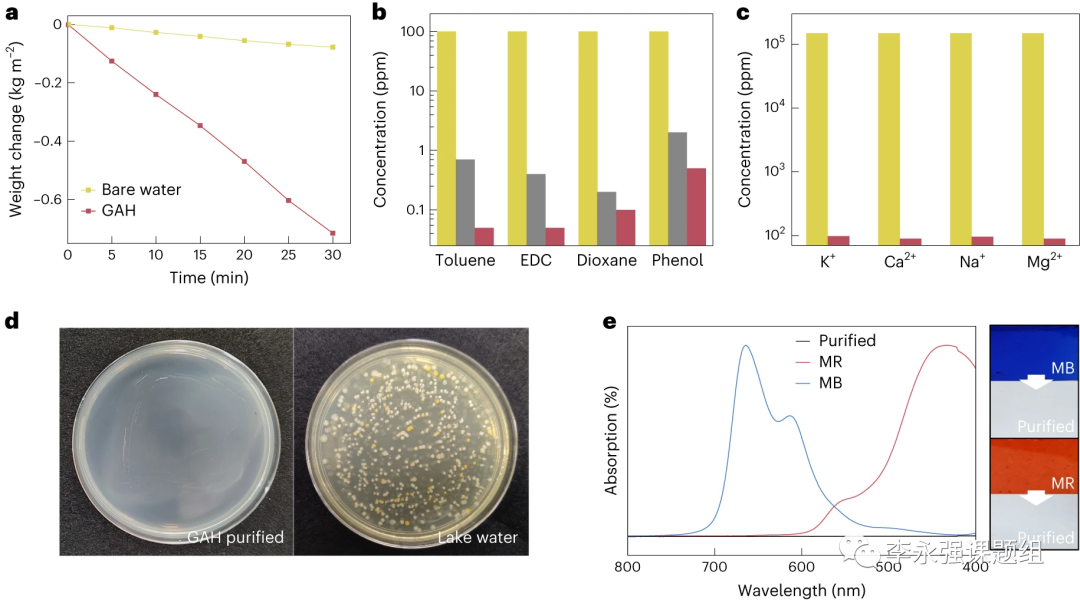

文献分享 | Nat. Water. | 具有高输送选择性和污垢抑制能力的多功能太阳能集水器
大家好,今天为大家分享一篇清华大学曲良体等人近期发表在Nat. Water.上的文章。作者开发了一种基于太阳能的石墨烯/海藻酸盐水凝胶(GAH)洁净水提取器,它具有高选择性的水传输特性,可阻隔99.5 %以上的挥发性有机化合物、99.3 %以上的离子(Na+、Mg2+、K+和Ca2+)以及100 %的非挥发性有机化合物和细菌。并且,GAH还能在水下形成大于140°的接触角以阻隔油类附着,杀灭表面约100 %的细菌,并防止盐结晶。该研究对于推广太阳能清洁水收集技术和解决受污染的水环境问题具有重要价值。

01
背景介绍
废油、挥发性有机化合物(VOC)、重金属离子和微生物等工业排放物正在不间断地污染地表水。同时,洁净水的短缺问题愈发严重,约每三个人中就有一人无法获得安全的饮用水。目前,热蒸馏和基于膜的反渗透技术已经被开发且投入使用,用于分离水中的污染物,以满足人类日益提高的生活水平。然而,高能耗、复杂的处理过程、沉重的经济负担以及燃料燃烧或废膜所造成的二次污染限制了它们的实际应用,尤其是在发展中国家和地区。
太阳能是一种取之不尽、用之不竭、广泛分布且对环境友好的可再生能源,太阳能制水被认为是从海水或无法饮用的水中获取清洁水的一种绿色、可持续战略,能够满足世界各地对水的迫切需求。得益于石墨烯、聚吡咯和金属纳米颗粒等太阳能界面材料的最新发展,太阳能的高效利用和快速蒸汽生成动力学已得到证实。然而,当地表水中含有复杂的污染物时,太阳能制水系统与合格的集水设备存在显著差距。例如,广泛分布于地表水中的挥发性有机化合物(VOCs,如二氯甲烷、甲苯和苯酚)很容易通过普通的太阳能界面材料转移到所生产的水中,而VOCs即使在极低浓度下对人体也是十分有害的。此外,非挥发性有机化合物(NOC)通常以油的形式存在,会堵塞太阳能界面材料的孔隙,限制水的传输。并且,地表水中存在的大量细菌会附着在太阳能界面材料的表面,使其失效。所有这些因素都会导致太阳能洁净水的生产率急剧下降。
02
设计思路
在此,作者设计了一种结合超致密内部结构和仿生表面工程(鱼鳞状微纳米多尺度图案)的石墨烯/铝酸盐水凝胶(GAH)。GAH在太阳能驱动的纯水收集中表现出高选择性,对含有复杂污染物的地表水具有多效防污能力。针对VOCs,水总是会携带污染物通过微孔通道到达蒸发表面,导致蒸汽不纯。由于GAH内部并不存在明显的穿透性微/纳米通道,因此,水分子只能先通过氢键变成与聚合物链结合的状态,然后逐渐通过形成的氢键扩散到另一侧,避免了大体积水迁移所引起的污染物附着(图1a)。对于其他有机化合物,由于大多数污染物与GAH之间的偶极-偶极相互作用较弱,因此大多数污染物分子很难与聚合物链形成足够的氢键并进入GAH(图1b)。除此以外,GAH和受污染的地表水之间具有较高的渗透压差,实现了离子的排斥(图1c)。在鱼鳞状石墨烯微纳米结构表面的帮助下,GAH通过高效率捕获入射光提高了太阳能-热能转换能力(图1d),并通过亲水性微纳米结构实现了超疏油性(图1e),且暴露在外的还原氧化石墨烯(rGO)纳米片具有抗微生物特性(图1f)。因此,GAH可从受污染的地表水中收集干净的水,拦截大于99.5 %的挥发性有机化合物、99.3 %的离子(Na+、Mg2+、K+和Ca2+)以及100 %的非挥发性有机化合物和细菌。此外,GAH的水下油接触角大于140°,具有抑制油附着的作用,表面抗菌效果也接近100%,对海水的离子抑制率为94.9%,在复杂的环境下具有理想的防污能力。

图1、GAH在洁净水生产中的优势
03
工作要点

图2、GAH的制造和表征

图3、GAH-3中的结合水状态
图4、GAH在收集洁净水过程中GAH的选择性

图5、GAH的超级防污性能

图6、GAH的离子排斥机理和实际性能
04
工作总结
作者成功开发了一种太阳能集水GAH系统,该系统具有高选择性的水传输和多功能的防污效果,可直接从含有复杂污染物的污水中获取洁净水。在仿生鱼鳞状表面工程和超致密rGO/海藻酸盐网络的辅助下,GAH具有(1)结构增强型的高效太阳热能转换,在一个标准太阳光下可吸收95 %以上的太阳光,将表面加热到80 ℃;(2)高选择性的水传输,可阻挡99.5 %的挥发性有机物;(3)大接触角,达到防油粘附的目的;(4)优异的抗菌性,可使表面约100% 的细菌失活;(5)高渗透压,可拒绝海水中94.9 %的海水离子进入。GAH的开发对低碳净水战略的实际应用和解决全球饮用水危机方面具有重要的意义。
05
课题组主页
https://faculty.sdu.edu.cn/liyongqiang/zh_CN
